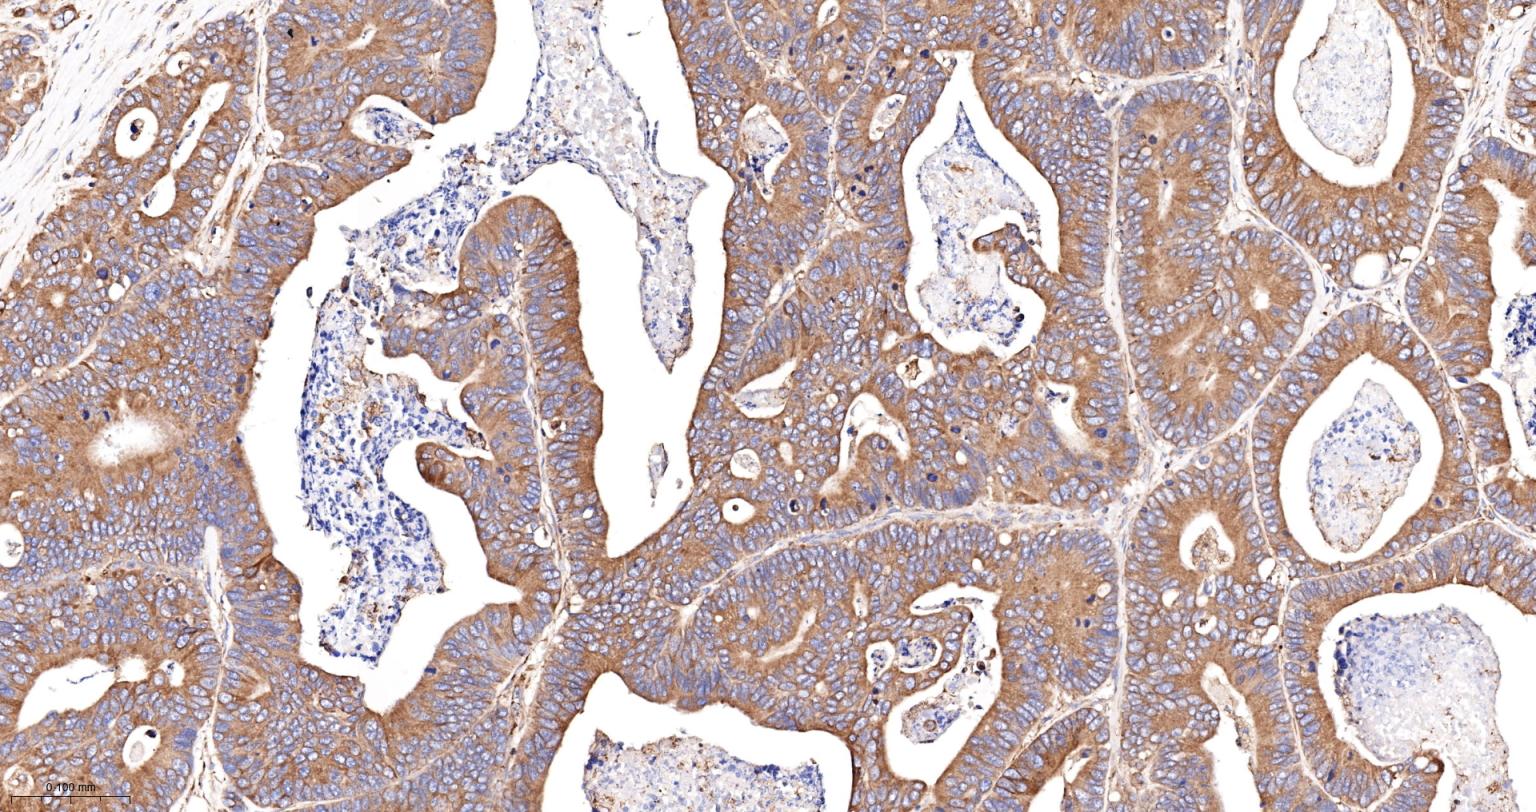
蛋白质二硫键异构酶重组兔单抗-bsm-62363R
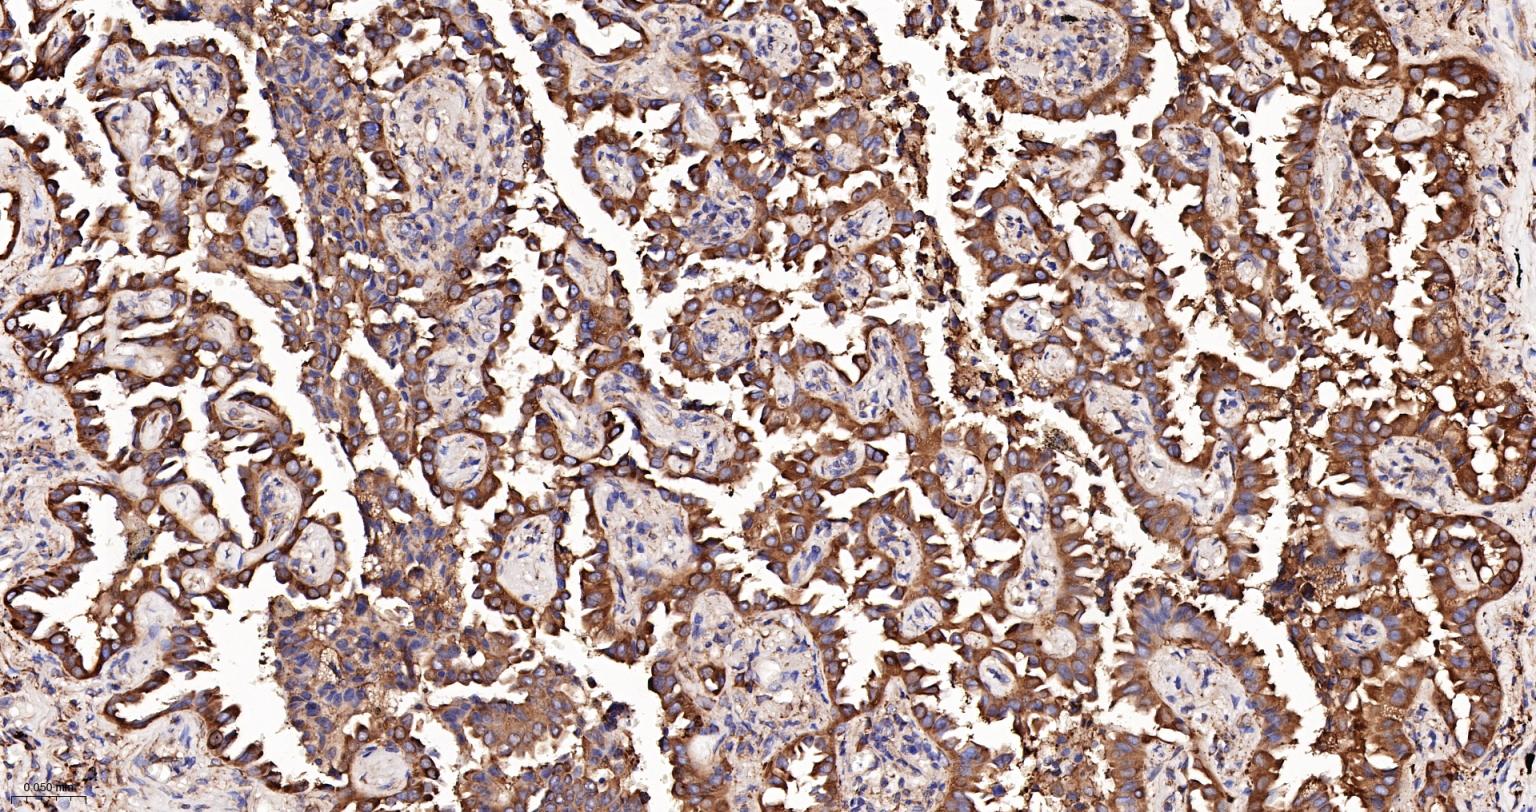
蛋白质二硫键异构酶重组兔单抗-bsm-62363R

P4HB Recombinant Rabbit mAb (一抗) - WB,IHC-P,IHC-F,IF,Flow-Cyt,ICC/IF | Bioss

概述
Cancer > Cancer Metabolism > Metabolic signaling pathway > Metabolism of lipids and lipoproteins
Cancer > Cancer Metabolism > Response to hypoxia
Metabolism > Pathways and Processes > Metabolic signaling pathways > Lipid and lipoprotein metabolism > Lipid metabolism
Metabolism > Pathways and Processes > Metabolism processes > Hypoxia
Metabolism > Types of disease > Cancer
Signal Transduction > Cytoskeleton / ECM > Extracellular Matrix > ECM Proteins > Collagen
Signal Transduction > Protein Trafficking > Chaperones > Other Chaperones
This multifunctional protein catalyzes the formation, breakage and rearrangement of disulfide bonds. At the cell surface, seems to act as a reductase that cleaves disulfide bonds of proteins attached to the cell.

产品应用
| 应用 | 已检合格种属 | 预测种属 | 推荐稀释比例 |
|---|---|---|---|
| WB | Human, Mouse, Rat | 1:1000-2000 | |
| IHC-P | Human, Mouse, Rat | 1:100-500 | |
| IHC-F | Human, Mouse, Rat | 1:100-500 | |
| IF | Human, Mouse, Rat | 1:100-500 | |
| Flow-Cyt | Human | Mouse, Rat | 1:100-200 |
| ICC/IF | Human | Mouse, Rat | 1:100-200 |
交叉反应
交叉反应: Human, Mouse, Rat
相关产品
暂无相关产品
靶标
Contains 2 thioredoxin domains.